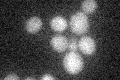
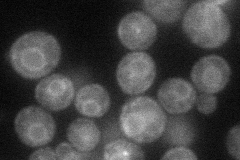

View description
Zinc finger protein containing five transmembrane domains; null mutant exhibits strongly fragmented vacuoles and sensitivity to brefeldin A, a drug which is known to affect intracellular transport
Localization:
Intensity:
Fold change:
Significance:
-
C’ GFP library in SD
below threshold16.42 -
N' NOP1pr-GFP in SD
cell periphery,ER42.5081 -
N' TEF2pr-mCherry in SD

cell periphery,vacuole75.8322 -
N' NATIVEpr-GFP in SD

below threshold17.6918 -
N' TEF2pr-VC and Cyto-VN in SD

below threshold28.5942 -
C’ GFP library in SD+DTT

punctate16.140.98No -
C’ GFP library in SD+H2O2

cytosol20.091.22No -
C’ GFP library in Starvation Media

cytosol17.991.09No -
C’ GFP library on the background of Pup2-DaMP

below threshold -
C’ GFP library on the background of CCT mutant

below threshold19.17651.16711No
